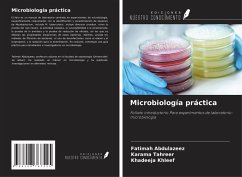

Suchergebnisse für "Ediciones Nuestro Conocimiento"
5000 Artikel gefunden
Zur ersten SeiteZur vorherigen Seite...Weitere Seiten 17 Zur Seite 17 18 Zur Seite 18 19 Zur Seite 19 20 Aktuelle Seite 21 Zur Seite 21 22 Zur Seite 22...Weitere Seiten99+Zur letzten Seite, Seite 100Zur nächsten SeiteZur letzten Seite
Zur ersten SeiteZur vorherigen Seite...Weitere Seiten 19 Zur Seite 19 20 Aktuelle Seite...Weitere Seiten99+Zur letzten Seite, Seite 100Zur nächsten SeiteZur letzten Seite
Ähnlichkeitssuche: Fact®Finder von OMIKRON